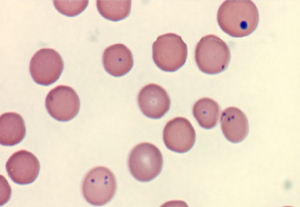

Микоплазмоз у собак

- Как понять, что у собаки микоплазмоз
- Диагностика микоплазмоза
- Как лечить микоплазмоз
- Как предотвратить заболевание собаки микоплазмозом
Микоплазмоз собак – это группа инфекционных заболеваний, вызываемых микроорганизмами (бактериями, не имеющими клеточной стенки) класса Mycoplasma. Представители класса могут быть паразитарными (патогенными), сапротрофными (обитающими как в организме, так и во внешней среде), и комменсалами (безвредными сожителями).
Микоплазмы часто выделяются при исследовании смывов со слизистых оболочек здоровых животных, причем их видовая идентификация, позволяющая утверждать, безобиден данный возбудитель или является причиной заболевания, затруднена. Однако, если есть характерные признаки заболевания и в анализах обнаруживаются микоплазмы – именно микоплазменную инфекцию принято считать причиной.
Как понять, что у собаки микоплазмоз
Клинические признаки микоплазмоза чаще обнаруживаются у ослабленных животных, или у щенков. Часто микоплазмы у таких животных соседствуют с хламидиями и герпесвирусом.
К наиболее характерным признакам микоплазмоза у собак относятся:
- конъюнктивиты с гнойными выделениями из глаз
- ринит с водянистыми, а позже слизисто-гнойными выделениями из носовых ходов
- хромота, вызванная артритами (воспалением суставов)
- цистит, уретрит - вагинит, эндометрит
- простатит
- пневмония (преимущественно у щенков)
- подкожные абсцессы
Микоплазмоз может приводить к бесплодию и невынашиванию беременности у племенных животных.
Микоплазмоз может приводить к бесплодию и невынашиванию беременности у племенных животных. Неспецифические признаки микоплазмоза включают в себя повышение температуры тела, вялость, снижение активности.
Диагностика микоплазмоза
Для диагностики микоплазмоза берутся смывы с пораженных слизистых оболочек и исследуются методом ПЦР, который позволяет выявить генетический материал возбудителя, даже если в материале для анализа его очень мало.
Как лечить микоплазмоз
Для лечения микоплазмоза применяются антибиотики, к которым чувствительны возбудители: тетрациклины, фторхинолоны, аминогликозиды, макролиды. Лечение микоплазмоза длительное. Прерывать прием антибиотиков, даже если животному стало лучше, категорически нельзя до завершения полного курса лечения.
Помимо антибиотикотерапии, при конъюнктивитах и, иногда, ринитах также требуется местная обработка для поддержания чистоты глаз и носа и улучшения самочувствия питомца.
При необходимости применяются препараты для симптоматической терапии (уменьшения проявления признаков заболевания).
Как предотвратить заболевание собаки микоплазмозом

Вакцин от микоплазмоза не существует, поэтому профилактика заболевания у собак сводится к препятствованию общения собаки с бродячими собаками и кошками и укреплению иммунитета (рациональное кормление, достаточный моцион).
При появлении у собаки признаков заболевания срочно покажите ее ветеринарному врачу. Для назначения адекватного лечения микоплазмоза у собаки требуется лабораторное подтверждение диагноза.
(с) Ветеринарный центр лечения и реабилитации животных "Зоостатус".
Варшавское шоссе 125 стр.1. тел. 8 (499) 372-27-37
Варшавское шоссе 125 стр.1. тел. 8 (499) 372-27-37
Почитайте отзывы о нашем ветеринарном центре.
Позвоните по номеру 8 (495) 241 64 95 и запишитесь на консультацию прямо сейчас.
(с) Ветеринарный центр лечения и реабилитации животных «Зooстатус».
Варшавское шоссе, 125 стр.1.


